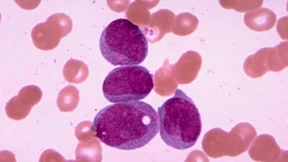
Neuer Wirkstoff gegen akute myeloische Leukämie entdeckt

Die Krebskiller werden jetzt im Körper rekrutiert
Das Immunsystem gegen den Tumor hochzurüsten ist bisher extrem aufwendig. Nun waren Versuche erfolgreich, CAR-T-Zellen direkt im Körper zu programmieren. Das könnte die Behandlung erschwinglicher machen.